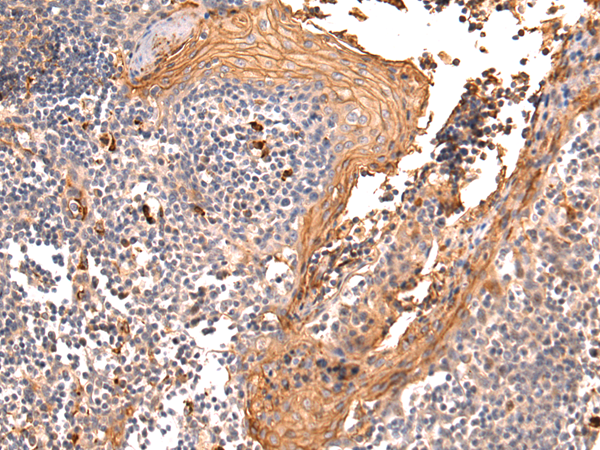

别名:CD67; CGM6; CD66b; NCA-95应用:WB,IHC
反应种属:Human
规格:50μl/100μl
| Description |
|---|
| Cell surface glycoprotein that plays a role in cell adhesion in a calcium-independent manner (PubMed:8776764, PubMed:2022629, PubMed:11590190). Mediates heterophilic cell adhesion with other carcinoembryonic antigen-related cell adhesion molecules, such as CEACAM6 (PubMed:8776764, PubMed:2022629, PubMed:11590190). Heterophilic interaction with CEACAM8 occurs in activated neutrophils (PubMed:8776764). By probing white blood cell cDNA libraries with tumor nonspecific crossreacting antigen, Arakawa et al. (1990) isolated a cDNA encoding CEACAM8, which they called NCA-W272. The deduced 349-amino acid protein contains 11 potential N-glycosylation sites and 4 cysteines expected to form 2 intramolecular disulfide linkages. It also has a signal peptide and several domains similar to those of other CEA family proteins, such as CEACAM1 (109770). Immunoblot analysis showed expression of a 70-kD protein that was reduced to a 37-kD major protein and a 34-kD minor protein in the presence of a glycosylation inhibitor. |
| Specification | |
|---|---|
| Aliases | CD67; CGM6; CD66b; NCA-95 |
| Swissprot | P31997 |
| WB Predicted band size | 38 kDa |
| Host/Isotype | Rabbit IgG |
| Storage | Store at 4°C short term. Aliquot and store at -20°C long term. Avoid freeze/thaw cycles. |
| Species Reactivity | Human |
| Immunogen | Fusion protein of human CEACAM8 |
| Formulation | pH7.4 PBS, 0.05% NaN3, 40% Glycerol |
| Application | |
|---|---|
| WB | 1/200-1/1000 |
| IHC | 1/50-1/100 |
| ELISA | 1/5000-1/10000 |
![]() |
Gel: 8%SDS-PAGE, Lysate: 40 μg, Lane 1-2: A431 and HepG2 cell lysates, Primary antibody: P07188(CEACAM8 Antibody) at dilution 1/500, Secondary antibody: Goat anti rabbit IgG at 1/5000 dilution, Exposure time: 2 minutes |
![]() |
The image is immunohistochemistry of paraffin-embedded Human cervical cancer tissue using P07188(CEACAM8 Antibody) at dilution 1/50. (Original magnification: ×200) |
![]() |
The image is immunohistochemistry of paraffin-embedded Human tonsil tissue using P07188(CEACAM8 Antibody) at dilution 1/50. (Original magnification: ×200) |
本公司的所有产品仅用于科学研究或者工业应用等非医疗目的,不可用于人类或动物的临床诊断或治疗,非药用,非食用。
暂无评论
本公司的所有产品仅用于科学研究或者工业应用等非医疗目的,不可用于人类或动物的临床诊断或治疗,非药用,非食用。
中文

发表回复